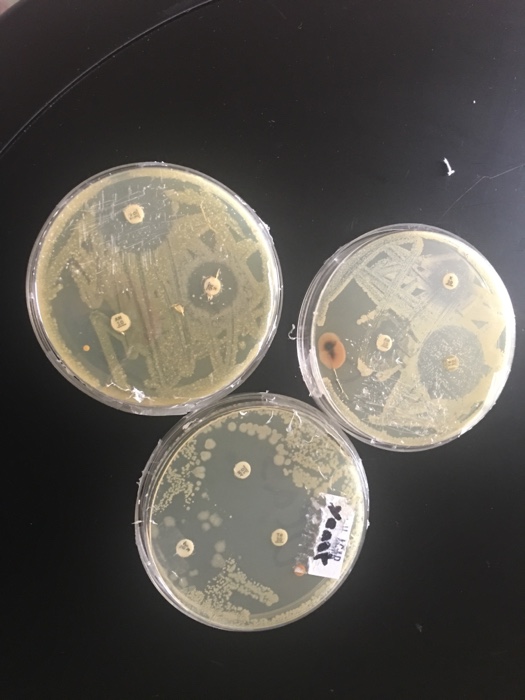

43 coupon for chegg textbooks
Chegg Study Promo Codes 2022 | 33% OFF Coupons, Coupon Codes $5 Off Your First Month's Chegg Subscription It' as easy as a pie to get your favorites by spending less money. Chegg Study provides a broad option of Education Software at an affordable price. Chegg Study codes is in your hands. Use it before it's gone. MORE+ Expires: Jun 25, 2022 27 used Last used 6 days ago Get Code ig 40% OFF 40% Off Your Order $5 Off Chegg Coupons & Coupon Codes | June 2022 - Groupon Chegg Coupons $5 Off [Missing js.modules.shared.CodeOfferType] $5 Off Your 1st Month (Chegg Coupon Code) Subscribe to Chegg today, & get $5 off your first month! Use this Chegg coupon code to save today. qso [missing en_US 'js.modules.shared.SeeCode' translation] [Missing js.modules.redemption.UsedCountFormat] Free Trial
90% OFF Chegg Coupon & Promo Code for June 2022 100 Chegg Coupons & Promo Codes are available now. Take 90% OFF by applying the best Coupon Code. ... Tap into Chegg's massive library of over 10 million step-by-step textbook solutions. Chegg. Get Code a97ab4370db86055d9f9f7db30939d-15% 15% Off All Orders. Chegg. Get Code E15-15% ...
Coupon for chegg textbooks
The Best Chegg Online Coupons, Promo Codes - Jun 2022 - Honey Get Coupon 8 Available Deals Sale Deal Tap into Chegg's massive library of over 10 million step-by-step textbook solutions Free Shipping Deal Earn cash selling your old textbooks to us + FREE shipping 90% OFF Deal Save up to 90% off Textbooks 90% off discount Sale Deal Over 500k eBook titles available Free Gift Deal 4 week free trial of Chegg Study coupons.cnet.com › coupons › chegg40% Off – Chegg Coupons – June 2022 What type of products does Chegg carry? Chegg carries Textbooks products. Which coupon for Chegg do customers use the most? The most frequently used Chegg discount code is Chegg Promo Code: 40% off. What sort of Chegg coupon codes are currently available? Right now, you can find 24 Chegg coupons online. 75% Off chegg.com Coupons & Promo Codes, April 2022 Save with Chegg Ebook Coupon & Promo codes coupons and promo codes for April, 2022. Today's top Chegg Ebook Coupon & Promo codes discount: Save 50% on AP Review Online From Kaplan ... Up to 90% Off Textbooks + Free Shipping Over $35+ Exclusions may apply. Act immediately before this Chegg coupon expires. Get Deal.
Coupon for chegg textbooks. Read Customer Service Reviews of - Trustpilot Chegg is your source for textbooks, study help, online tutoring, and more. We help students save time, save money, and get smarter! Contact. 1-855-581-9873; United States; Categories. Chegg is 147 out of 162 best companies in the category Association or Organization on Trustpilot. Chegg is 132 out of 139 best companies in the category Educational Institution on Trustpilot. … Chegg Coupons: Coupon Codes, Promos 2022 - RetailMeNot.com Chegg's philanthropic efforts, in association with American Forests, have resulted in the planting of more than 1.5 million trees for every book rented, bought or sold. This semester, save even more on books and classroom help with the Chegg coupon codes below. 40% Off – Chegg Coupons – June 2022 How do I use my Chegg coupon code? Choose the coupon code that saves the most for your order. Head to Chegg and add textbooks or services to your cart. Enter the cart page and find a section labeled "Add Promo Code." Add the code, select "Apply," and get the discount. What can I do if my Chegg coupon code isn't working? Ensure the code was ... Chegg Coupons/ Free Trial - June 2022 - Super Easy When you need textbooks, Chegg is a place that saves you some money. Rent or buy your college textbooks from Chegg to get savings of as much as 90% off on physical textbooks. eTextbooks are also available with access anytime, anywhere, and across all connected devices. You can search, highlight, take notes & see key highlights from other students.
Textbooks - Cheap Textbooks - Textbook Rental | eCampus.com Don't pay full price for textbooks. Save money on cheap textbooks and textbook rentals at eCampus.com. Get fast, free shipping on orders over $35. Chegg Coupons, Coupon Codes, and Promo Codes June 2022 11.05.2022 · For Chegg, users can get up to 90% off on all subjects include: Physics, Chemistry, Math, Engineering, Business Law, etc. Get amazing discounts and deals on E-textbooks for various subjects. Chegg coupon codes can be merged to get extra benefits. So be prepared to have up to 90% discount on textbooks. Chegg Coupons/Coupon Codes April 2022 Chegg Coupons 20% Off 2022 - HotDeals.com Try discounts on Chegg shopping to get discounts on Book Rental when order Book Rental online. Save big bucks w/ this offer: Coupon Code for 20% Off $40. Save with hotdeals.com today…. Expires: Jul 2, 2022 3 used Last used 8 days ago. Chegg Coupons/ Free Trial - June 2022 - Super Easy 30.05.2022 · Chegg not only releases special deals but also study tips to their followers on their social media. Sometimes, they’ll give deal information and giveaways. So follow and like Chegg on Facebook, don’t miss the deals. 4. Sell your old textbooks. If you have useless old textbooks, sell old textbooks to Chegg will let you earn some extra cash ...
Chegg ($10 Off Coupon) & Coupon Codes Jun 2022 - Slickdeals Chegg Coupons and Promo Codes | June 2022 CODE Coupon Free Shipping With This Coupon Coupon Verified! 1 Used Today Get Coupon Code 90% off Sale Up to 90% Off Textbooks + Free Shipping Over $30+ Offer Verified!2 used today Get Offer $10 off Coupon Save $10 Off With This Promo Code Coupon Verified! 2 Used Today Get Coupon Code SALE Sale 30% Off | Chegg Coupons | March 2022 Chegg student discount. There is a Chegg student discount: Students receive 30 days of Chegg Study for free. The program provides in-depth explanations of how to do math problems, written assignments, and more. After the free 30 days, it's $14.95 a month. Students can also take advantage of Chegg promotions or use coupons. Chegg Coupons | Jun 2022 | Verified Chegg Coupons and Discount Codes For June 2022 - View all the best discount codes and coupons for Chegg. Enjoy instant savings at chegg.com using functioning deals for June 2022 ... Chegg.com wants to make sure you never pay full price for textbooks, and Chegg's is all about taking away the obstacles that stand in the way of education. In ... 50% Off Chegg Coupons & Promo Codes | June 2022 Save up to 50% off with our best Chegg coupon. Get 50% Off On Chegg Study Pack Subscription with code CHEGGXSE. Highest ever Chegg discount: Take $248.21 Off On The Economics Today 18th Edition. Latest Chegg Offer: Save Up To 90% On Textbooks1. Our coupons save shoppers an average of $45 at Chegg. On average we discover a new Chegg discount ...
Cheap Textbooks & Textbooks Sales June 2022 - Groupon Top Dollar Textbook Buyback | Chegg Coupon. Put money back into your wallet with Chegg! Sell your old text books and get back top dollar for your gently used books. Get Deal. View terms. Promo eTextbooks For Less | Chegg Coupon. Access your reading materials with any connected device! Now you can search, highlight, or take notes with Chegg's ...
Chegg Coupons - 25% OFF in June 2022 Like ordering physical textbooks, you can also get e-textbooks from Chegg. Flexible rental costs for e-books start at $6.99 per month. Chegg's e-book reader platform gives you access to over four-hundred-thousand titles. With typical school bookstore prices, choosing e-books can save you hundreds of dollars. Add one of our Chegg coupons and save even more. Chegg …
Chegg Coupons | 25% Off In June 2022 | Forbes Save up to 25% Off your next Chegg order. Save money with 25 current Chegg coupon codes verified today for June 2022. All offers are hand-picked & tested.
Chegg - Wikipedia Chegg, Inc., is an American education technology company based in Santa Clara, California.It provides digital and physical textbook rentals, textbooks, online tutoring, and other student services. The company was launched in 2005, and began trading publicly on the New York Stock Exchange in November 2013. As of March 2020, the company reported having 2.9 million …
50% Off Chegg Coupons & Promo Codes - June 2022 25% Off Chegg Coupons & Promo Codes - June 2022 You've earned $0 in cashback . Sign up to activate! Chegg Coupons, Promo Codes and Cash Back 6 Verified Coupons for June 24, 2022 Earn up to 50% Cash Back at Chegg No expiration Sign Up CODE ON SALE Coupon Code for Free Shipping on Orders Over $35 expires: ongoing
Chegg | Sell Textbooks SELL YOUR TEXTBOOKS Sell your books, earn some cash. Done with your book? Make some money by selling it with GoTextbooks. Get started Get started Get started done loading. How it works . Check the value. Just enter the textbook ISBN and see what you'll be paid for your used textbook. Ship for free. Print your free shipping label, then ship your book to GoTextbooks. Get …
55% Off chegg.com Coupons & Promo Codes, June 2022 Chegg Etextbook Coupon & Promo codes TOP COUPONS Great Offer Verified Free Shipping on Physical Textbook Orders of $50+ Click to enjoy the Chegg discount and great offer to save. Don't skip this good chance to save! Get Code Great Offer Verified Get subscription for only $19.95/month. More tools, better grades! No code is necessary.
Chegg Coupon | Chegg.com Looking for a Chegg coupon? Check back soon! Many online sites offer Chegg coupons or discount codes, but at Chegg you'll always find the latest and greatest coupons.
75% Off chegg.com Coupons & Promo Codes, April 2022 Save with Chegg Ebook Coupon & Promo codes coupons and promo codes for April, 2022. Today's top Chegg Ebook Coupon & Promo codes discount: Save 50% on AP Review Online From Kaplan ... Up to 90% Off Textbooks + Free Shipping Over $35+ Exclusions may apply. Act immediately before this Chegg coupon expires. Get Deal.
coupons.cnet.com › coupons › chegg40% Off – Chegg Coupons – June 2022 What type of products does Chegg carry? Chegg carries Textbooks products. Which coupon for Chegg do customers use the most? The most frequently used Chegg discount code is Chegg Promo Code: 40% off. What sort of Chegg coupon codes are currently available? Right now, you can find 24 Chegg coupons online.
The Best Chegg Online Coupons, Promo Codes - Jun 2022 - Honey Get Coupon 8 Available Deals Sale Deal Tap into Chegg's massive library of over 10 million step-by-step textbook solutions Free Shipping Deal Earn cash selling your old textbooks to us + FREE shipping 90% OFF Deal Save up to 90% off Textbooks 90% off discount Sale Deal Over 500k eBook titles available Free Gift Deal 4 week free trial of Chegg Study

Post a Comment for "43 coupon for chegg textbooks"